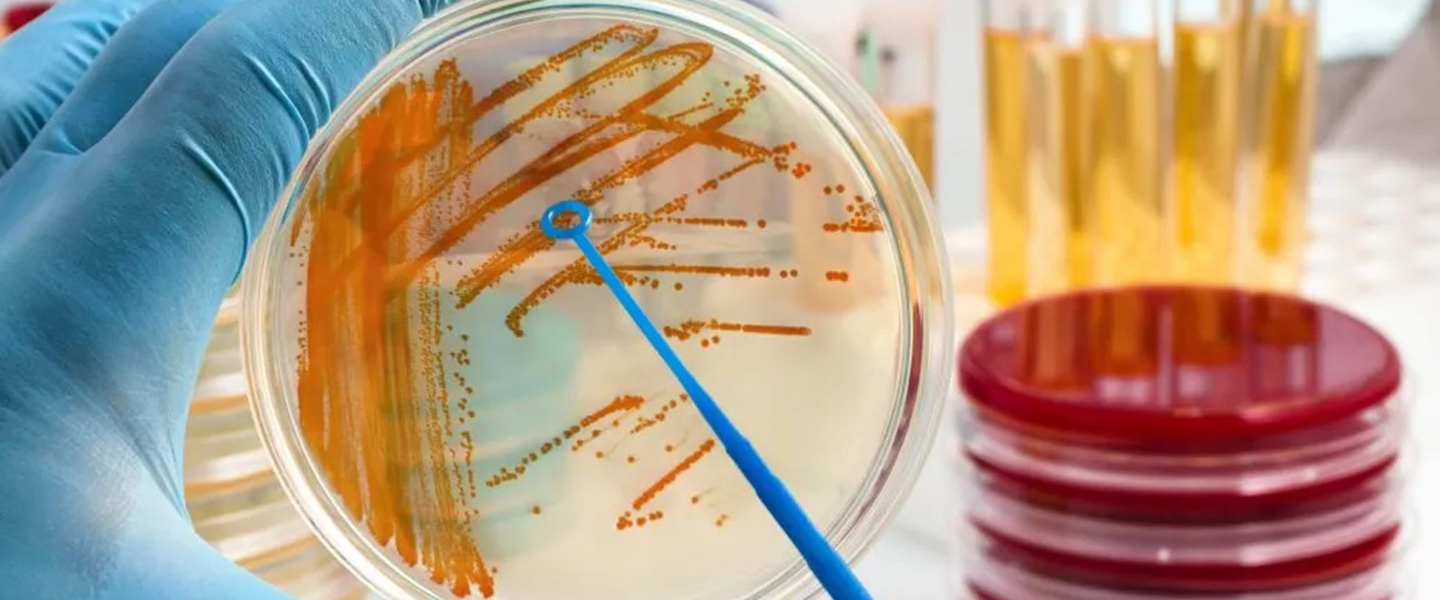
Microbiology Test

Microbiology Testing Services | Advanced Diagnostic Laboratory – ProLab
Accurate & Reliable Microbiology Testing at ProLab
ProLab offers comprehensive microbiology testing services to detect bacterial, viral, fungal, and parasitic infections. Our advanced diagnostic laboratory uses modern equipment and strict quality control protocols to ensure precise and timely test results.
Microbiology tests help doctors identify the exact cause of infections and recommend the most effective treatment.
What is Microbiology Testing?
Microbiology testing is a laboratory process that examines blood, urine, sputum, stool, wound swabs, and other body samples to detect harmful microorganisms. These tests play a vital role in diagnosing infectious diseases and monitoring treatment response.
Our Microbiology Test Services
At ProLab, we provide a wide range of microbiological investigations, including:
- Blood Culture Test
Detects bacteria or fungi in the bloodstream to diagnose serious infections.
- Urine Culture Test
Identifies urinary tract infections (UTIs) and determines the appropriate antibiotic.
- Sputum Culture Test
Used to diagnose respiratory infections, including tuberculosis and pneumonia.
- Stool Culture Test
Detects bacterial or parasitic infections affecting the digestive system.
- Wound Swab Culture
Identifies infection in wounds and helps determine antibiotic sensitivity.
- Antibiotic Sensitivity Test
Determines which antibiotics are most effective against specific bacteria.
Why Choose ProLab for Microbiology Testing?
Advanced Laboratory Equipment,
Experienced Microbiologists,
Accurate & Timely Reports,
Strict Hygiene & Quality Standards,
Affordable Pricing,
Home Sample Collection Available
When Do You Need a Microbiology Test?
Your doctor may recommend microbiology testing if you experience:
- Persistent fever
- Recurrent urinary infections
- Chronic cough or respiratory issues
- Digestive infections
- Non-healing wounds
- Suspected bacterial or viral infection
How to Prepare for a Microbiology Test?
Preparation depends on the type of test. Some tests may require:
- Fasting (if combined with other blood tests)
- Early morning sample collection (for sputum or urine)
- Avoiding antibiotics before testing (as advised by doctor)
Always follow your doctor’s instructions for accurate results.
Book Your Microbiology Test Today
ProLab makes testing simple and convenient. Visit our laboratory or book home sample collection for fast and reliable microbiology test results.
📞 Contact us +91-7986637578 today to schedule your test.
Frequently Asked Questions (FAQ) - Microbiology Test | Prolab
A microbiology test at ProLab is a laboratory examination used to detect bacteria, viruses, fungi, or parasites in blood, urine, stool, sputum, or other body samples. These tests help diagnose infections accurately and guide proper treatment.
Doctors recommend microbiology testing to identify the exact cause of infections such as urinary tract infections (UTIs), respiratory infections, digestive infections, wound infections, or bloodstream infections.
Most microbiology test reports are available within 24–72 hours. Some culture tests may take longer depending on the type of microorganism being identified.
Fasting is generally not required unless the test is combined with other blood investigations.
Yes, ProLab offers safe and hygienic home sample collection services for eligible microbiology tests to ensure convenience and comfort.